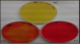

Copper and copper oxides are commonly used for their bactericidal and antimicrobial properties in various medical and sanitary equipment. The mechanism of antibacterial activity involves the continuous transfer of electrons, resulting in membrane rupture and increased oxidative stress. Although copper can cause changes to molecular structures and impair bacterial replication, it does not cause mutations in DNA.
In order to capitalize on copper’s antimicrobial properties, researchers synthesized and characterized the antimicrobial activity of cuprite, or copper (I) oxide (Cu2O), through a chemical route. Copper sulfate pentahydrate served as a precursor, and organic reductants ascorbic acid and glucose were utilized. They dissolved the precursor salt and organic reductant in distilled water and heated the solution to 70°C for 20 minutes to obtain an orange precipitate. The sample was then washed, dried, and labeled before being sent to external laboratories for analysis. The researchers used X-ray diffraction (XRD) and scanning electron microscopy (SEM) analysis to characterize the synthesized particles.

The use of glucose as a reductant resulted in the production of 100% cuprite with varying morphologies, including spheres, cubes, and tetrahedra, depending on the concentration of NaOH. The synthesized copper oxide had a particle size in the nanoscale and micrometer, indicating the presence of nanoparticles and Cu2O nanostructures.
Staphylococcus aureus, a gram-positive bacterium known for its virulence and antibiotic resistance, was chosen to test the microbicidal activity of Cu2O copper oxide. The Minimum Inhibitory Concentration (MIC) of the synthesized cuprite regarding S. aureus was determined to be 16 mg/mL, indicating its antimicrobial effect on Staphylococcus aureus bacteria.
The study’s findings demonstrate the potential of Cu2O copper oxide as an antimicrobial agent. Cu2O copper oxide could be a promising solution for preventing and treating microbial infections in the future. However, further studies are required to assess the safety and efficacy of these nanoparticles before they can be used clinically.
Link to the article: https://journals.modernsciences.org/index.php/msj/article/view/19
Summary of: Study of the Antimicrobial Activity of Cuprite Synthesized by Chemical Route, by Orfelinda Avalo Cortez et al
References
Avalo Cortez, O., & Martínez Aguilar, D. P. (2022). Study of the Antimicrobial Activity of Cuprite Synthesized by Chemical Route. Modern Sciences Journal, 11(1). https://doi.org/10.57184/msj.v11i1.19
